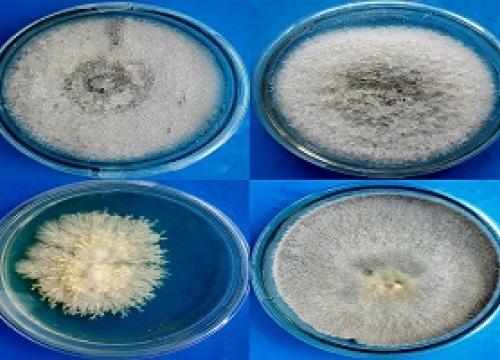
workshop

Ongoing Research Project
"Characteristic Mode Analysis for the Miniaturization of an Antipodal Vivaldi Antenna for the Application of Microwave Imaging of Brain". 2024
Dr. Farhana Parveen, Assistant Professor, Department of Electrical and Electronic Engineering, East West University. Ethical Clearance No. CRTEWU-REC-19(1)/2024
“Hidden Struggles in Rising Tides: Exploring Women's Access to Sexual and Reproductive Health Rights in Coastal Bangladesh During Disasters” 2024
Ms. Nabila Farhin, and Ms. Nadia Rahaman, Senior Lecturer, Department of Law, East West University. Ethical Clearance No. CRTEWU-REC-18(1)/2024
“The Role of Digital Literacy and Culture Specific Communication Skills among Expatriate Bangladeshi Domestic Workers” 2024
Dr. Mohammad Masudur Rahman, Assistant Professor, Department of Business Administration, East West University. Ethical Clearance No. CRTEWU-REC-18(2)/2024
Collaborator: Dr. Sabreena Ahmed, Associate Professor, Department of English and Humanities, BRAC School of Humanities and Social Sciences, BRAC University and Ms. Sharaban Tohura, Senior Specialist: Soft Skills, BRAC Skills Development Programme.
“Teaching Myanmar Curriculum in the World’s Largest Refugee Camp: A Critical Insight” 2024
Dr. Muhammed Shahriar Haque, Professor, Department of English, East West University. Ethical Clearance No. EWUCRT-REC-16(2)/2023
Comparative Pharmacological Study of the Oleanane Triterpenoids from Terminalia Arjuna in Non-alcoholic Steatohepatitis 2023
Dr. Rejina Afrin et. al, Department of Pharmacy, East West University

Performance Evaluation of Outcomes Based Undergraduate Engineering Programs – A Case Study of BSc in EEE program at East West University 2023
Dr. Muhammed Mazharul Islam and Dr. Anisul Haque, Department of Electrical and Electronic Engineering
“Phytochemical and Pharmacological Analysis of Secondary Metabolites of Endophytic Fungi associated with Few Medicinal Plants of Bangladesh” 2023
Dr. Nazia Hoque, Associate Professor, Dr. Sufia Islam, Professor, Ms. Nazifa Tabassum, Lecturer, Ms. Parisa Tamannur Rashid, Senior Lecturer, Ms. Shahnaz Siddiqua, Senior Lecturer, Department of Pharmacy, East West University
Carbon Based Materials Derived from Metal-Organic Frameworks (MOFs) and Their Application in Electrochemical Supercapacitors by Supercapacitors 2022
Dr. Md. Nazmul Abedin Khan et. al., Assistant Professor, Department of Mathematics and Physical Sciences, EWU
‘Numerical Analysis and Experimental Study of Various Cleaning Intervention Strategies for Soiling Affected Solar Panels to Maximize Revenue’ 2022
Dr. Ryyan Khan, Associate Professor, Department of Electrical and Electronic Engineering
Identification and Characterization of MDR, XDR and PDR Bacteria from Clinical Samples 2020
Dr. Md. Mohiuddin Kabir, Associate Professor, Department of Genetic Engineering and Biotechnology, East West University, Professor Dr. Chowdhury Faiz Hossain, Department of Pharmacy, East West University, Professor Dr. AM Zonaed Siddiki, Department of Pathology and Parasitology, Faculty of Veterinary Medicine, Chittagong Veterinary and Animal Sciences University, Chittagong , and Ms. Zinat Farzana, Lecturer, Department of Genetic Engineering and Biotechnology, East West University.
Collaborator: Department of Pathology and Parasitology, Faculty of Veterinary Medicine, Chittagong Veterinary and Animal Sciences University, Chittagong
- ‹ previous
- 2 of 2


